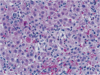

Liver and Biliary Flashcards
(43 cards)
- disoriented
- poor hygiene and odor of alcohol
- jaundice, splenomegaly and ascites
- asterixis
- spider angiomata
- ALT, AST, Alk Phos and Bilirubin mildly elevated
- Hematemesis
- liver biopsy shows nodular regeneration and scarring
What is the cause of the disorientation (hpatic encephalopathy)?
Cirrhosis with portal HTN causing esophageal varices and ascites (decreased oncotic pressure from hypoalbuminemia is also contributory)
-increased ammonia levels cause disorientation
- 2 week hx of jaundice and icterus
- similar episode 2 years ago
- borhter with recurrent jaundice
- increased unconjugated bilirubin
- ALT and AST normal
- Jaundice resolves spontaneously
Gilbert Syndrome
- recent hx of fatigue
- jaunidce and icterus
- increased unconjugated bilirubin
- Normal LFT’s
- anemic
- usually subsides with corticosteroid treatment
Autoimmune hemolytic anemia
- 2 week hx of fever, malaise, and brown urine
- recent visit to mexico
- jaundice, hepatosplenomegaly
- increased unconjugated bilirubin
- AST and ALT elevated
- IgM anti-HAV positive
- IgG anti-HBsAg positive
Acute Viral Hepatitis A
(IgG anti-HBsAg only means previous exposure)
- neonate with jaundice
- PE is unremarkable
- increased level of conjugated or unconjugated bilirubin?
unconjugated- just due to immaturity of the liver
- icterus and jaundice
- low grade fever for 1 month
- RUQ tenderness
- hepatomegaly
- AST, ALT and bilirubin elevated
- PT prolonged
- councilman bodies on biopsy, ballooning degeneration of hepatocytes, bile stasis, mononuclear inflammatory cell infiltrates
Acute Viral Hepatitis
- 9 month hx of fatigue and recurrent fever
- jaundice, dark urine, hepatomegaly
- elevated biliirubin, low albumin, prolonged PT
- IgG anti-HBcAg positive
- Positive HBsAg and HBeAg
What vascular inflammtory disease is this pt as risk for?

Chronic Hepatitis B
(B=transmission through banging)
Polyarteritis Nodosa
- vague abd pain
- indigestion
- obese woman with jaundice
- mild increase in ALT, AST and Alk phos
- markers for hepatitis negative
- echogenic stone like material in gall bladder and thickened gall bladder wall
- dense fibrosis and glandular structures in wall of gall bladder
Adenocarcinoma of the gallbladder
- dry mouth, fatigue, fever, icterus, mild jaundice, hepatomegaly
- negative viral hepatitis markers
- positive antinuclear antibodies
- biopsy shows parenchymal and periportal inflammatory cell infiltrates (mainly lymphocytes and plasma cells)
- goes away with steroid tx
Autoimmune hepatitis
- abd swelling, weight loss, upper abd pain
- hx of infection with liver fluke C. sinensis
- hypoattenuated mass with lobulated margins on liver
- well differentiated neoplastic glands embedded in fibrous dense stroma on biopsy
Cholangiosarcoma
- oliguria, azotemia, and increased creatinine levels
- longstanding alcoholic cirrhosis
- normal kindey biopsy
Hepatorenal Syndrome
(renal failure caused by vasoconstriction and hypoperfusion of kidneys)
- frequent indigestion after meals and abd pain
- moderately obese
- numerous echogenic objects in gallbladder
- gall bladder contains black stones
- this is associated with_________
cholelithiasis
associated wtih sickle cell disease (pigment stones form increased hemolysis)
- heroin addict
- 5 days of fatigue, malaise, and dark urine
- jaundice and multiple petechial hemorrhages
- high conjugated bilirubin levels
- High ALT, AST and ammonia
- prolonged PT
- condition rapidly deteriorates

Hepatitis B virus: biopsy shows massive hepatic necrosis
- sudden onset acute abd pain
- abd distension, tap returns blood
- CT shows solitary 20cm mass on liver
- tumor is encapsulated and paler than liver parenchyma
- associated with use of ________

Hepatic adenoma
use of contraceptives
- 2 month hx of fatigue, abd pain, jaundice and icterus
- hand tremor, lack of coordination, mild jaundice
- copper ring in decemet membrane of iris
Wilsons Disease
- icterus, abd pain, malaise, weight loss, low grade fever
- distended abd with RUQ pain
- decrease albumin, increased AST, ALT, and alk phos
- PT is prolonged
- leukocytosis
- hepatic steatosis, with hydropic swelling of hepatocytes

Alcoholic Hepatitis
- 6 month hx of itching, weight loss, fatigure, iterus
- mild jaundice and steatorrhea
- high cholesterol and alk phos
- no evidence of gallbladder obstruction
- antimitochondrial antibody test is positive
- xanthomas
- liver biopsy shows intrahepatic bile duct damage
Primary Biliary Cirrhosis
If a patient with fatty liver stops drinking what happens to the liver?
reverts to normal
- progressive skin pigmentation
- large amts of urine and always thirsty
- hepatomegaly
- GTT indicates chemical diabetes
- increased risk for Hepatocellular Carcinoma

Hereditary Hemochromatosis
- hx of increasing abd girth and pain
- smokes and takes oral contraceptives

Budd Chiari Syndrome
- 3 month hx of vague upper abd pain after fatty meals
- indigestion
- obese woman, multiple echogenic objects in gallbladder
- yellow stones
- What is a common complication of this?
Cholesterol gallstones caused by increased hepatic cholesterol secretion
-extrahepatic biliary obstruction
- vague abd pain
- intermittent fever
- weight loss
- hx of chronic hepatitis B
- hepatomegaly and jaundice
- diffusely nodular liver with a dominant mass
- marker for progression if AFP
Hepatocellular Carcinoma
How is damage to the liver best assesed?
liver biopsy
- hx of industrial solvent use
- clouded sensorium and lethargy
- extremely high ALT
- dies in hepatic coma
Toxic Liver Injury




